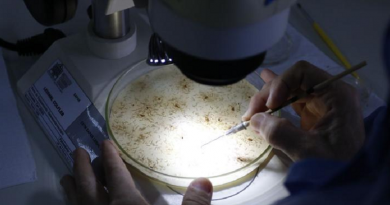
pesquisadores

PF retira invasores de terra indígena e desmonta extração ilegal de madeira
A operação contou com a colaboração do Ibama, da Funai, do Exército Brasileiro e da Força Nacional – (crédito: Divulgação/Polícia Federal)
Esta é a quinta operação realizada na TI Igarapé Lage neste ano. A área desmatada no local alcança 840 hectares, que corresponde a 800 campos de futebol.
A Polícia Federal retirou, na quarta-feira (5/6), três invasores da Terra Indígena Igarapé Lage, na região oeste de Rondônia. Além disso, foram apreendidos um gerador e um maquinário pesado usados na extração ilegal de madeira. Os equipamentos são avaliados em cerca de R$ 2 milhões. Também foram apreendidos cerca de 140 metros cúbicos de madeira, avaliados em R$ 70 mil.
As ações ocorreram no âmbito da operação Retomada III, que contou com a colaboração do Instituto Brasileiro do Meio Ambiente e dos Recursos Naturais Renováveis (Ibama), da Fundação Nacional dos Povos Indígenas (Funai), do Exército Brasileiro e da Força Nacional. A operação é a quinta realizada pela Polícia Federal na TI Igarapé Lage neste ano. A área desmatada no local alcança 840 hectares, extensão que corresponde a aproximadamente 800 campos de futebol.
“Os invasores haviam criado um grande corredor de ponta a ponta da reserva, com extensão de aproximadamente 20 km, além de construir várias pontes, uma delas com mais de 240 m de extensão. Todas essas estruturas foram destruídas nas ações realizadas ao longo do ano”, informou a PF.
Policiais Federais também verificaram a delimitação criminosa de parte da TI Igarapé Lage em cerca de 100 lotes, o que configura prática de grilagem de terras.
Os responsáveis pelos atos ilícitos podem ser condenados pelo crime de invasão de terras públicas com intenção de ocupação e pelo crime de desmatamento clandestino em área pública, ficando sujeitos a penas de detenção por até 3 anos e de reclusão por até 4 anos, respectivamente.
Fonte: Correio Brasiliense e Publicado Por: Jornal Folha do Progresso em 07/06/2024/12:12:31
O formato de distribuição de notícias do Jornal Folha do Progresso pelo celular mudou. A partir de agora, as notícias chegarão diretamente pelo formato Comunidades, uma das inovações lançadas pelo WhatsApp. Não é preciso ser assinante para receber o serviço. Assim, o internauta pode ter, na palma da mão, matérias verificadas e com credibilidade. Para passar a receber as notícias do Jornal Folha do Progresso, clique no link abaixo e entre na comunidade:
* Clique aqui e acesse a comunidade do JORNAL FOLHA DO PROGRESSO
Apenas os administradores do grupo poderão mandar mensagens e saber quem são os integrantes da comunidade. Dessa forma, evitamos qualquer tipo de interação indevida. Sugestão de pauta enviar no e-mail:folhadoprogresso.jornal@gmail.com.
Envie vídeos, fotos e sugestões de pauta para a redação do JFP (JORNAL FOLHA DO PROGRESSO) Telefones: WhatsApp (93) 98404 6835– (93) 98117 7649.
“Informação publicada é informação pública. Porém, para chegar até você, um grupo de pessoas trabalhou para isso. Seja ético. Copiou? Informe a fonte.”
Publicado por Jornal Folha do Progresso, Fone para contato 93 981177649 (Tim) WhatsApp:-93- 984046835 (Claro) -Site: www.folhadoprogresso.com.br e-mail:folhadoprogresso.jornal@gmail.com/ou e-mail: adeciopiran.blog@gmail.com